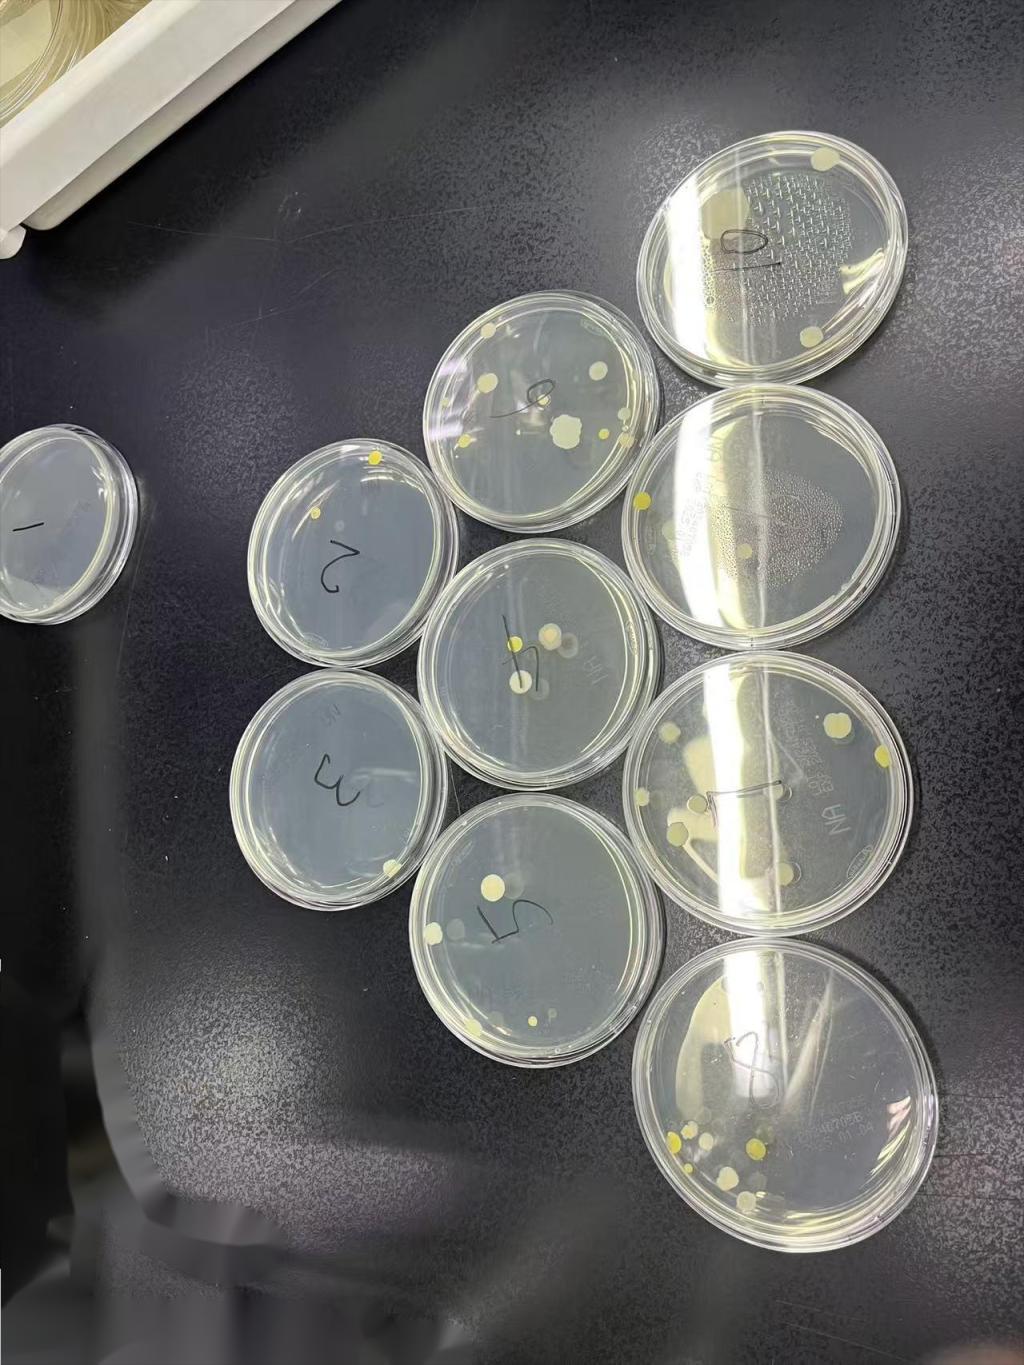

电话:029-87679000(总机)
地址:陕西省西安市西五路157号
邮编:710114
网址:www.2yuan.xjtu.edu.cn
为全面追踪我院呼吸机内管路消毒效果,医务部医院感染管理办公室2024年8月1日-8月8日及10月16日两个时间段分别开展了呼吸机消毒效果专项横断面采样工作。此次专项工作采取细胞培养中常见的微生物污染检测ATP荧光法进行快速检测。共对我院11个ICU病区56台呼吸机及麻醉科7台麻醉呼吸机进行了采样。采样的项目主要为呼吸机内部管路进口和出口4CM深度的内表面等。




通过检测发现呼吸机内管路吸入端染菌率为50.81%,呼出端染菌率39.34%,呼吸机和麻醉机的内管路存在染菌的风险,消毒后的吸入端和呼出端存在随着放置时间越长染菌风险越大的特点。由于呼吸机和麻醉机的机构特殊,内部的一些部件无法正常拆卸,无法进行常规方式的消杀,存在交叉感染的风险。因此呼吸机内管路的清洁消毒也成为院感防控的重点和难点。
对于此次采样存在感染风险的呼吸机,现场将结果反馈给科室,针对不同厂家的仪器出现的问题,院感科专职人员联合使用科室进行了点对点原因分析及清洁消毒质量质控。由于各厂家生产的呼吸机结构略有不同,根据不同的品牌,通过制定合适的清洁与消毒SOP,使用管路消毒机对呼吸机内管路进行消毒,对比消毒前后效果等措施提高呼吸机管路消毒效果。此外还通过定期或不定期开展清洁与消毒(灭菌)质量监测,包括微生物学监测,确保临床一线医疗工作安全。

通过此次专项横断面采样对我院的呼吸机内部管路的清洁消毒状况有了更深一步的了解,形成专项调查报告1份,为做好呼吸机相关肺炎(VAP)的防控,落实《医院感染管理医疗质量控制指标(2024年版)》--降低呼吸机相关肺炎发病率(HAIQI-VAP-10)提供了有力依据和思路。综合此次专项采样工作结果,呼吁更多使用科室关注呼吸机内部管路系统的清洁消毒,做好呼吸机管路清洁消毒质控工作,让呼吸机真正达到由内而外的清洁,以降低医院感染的发生率。